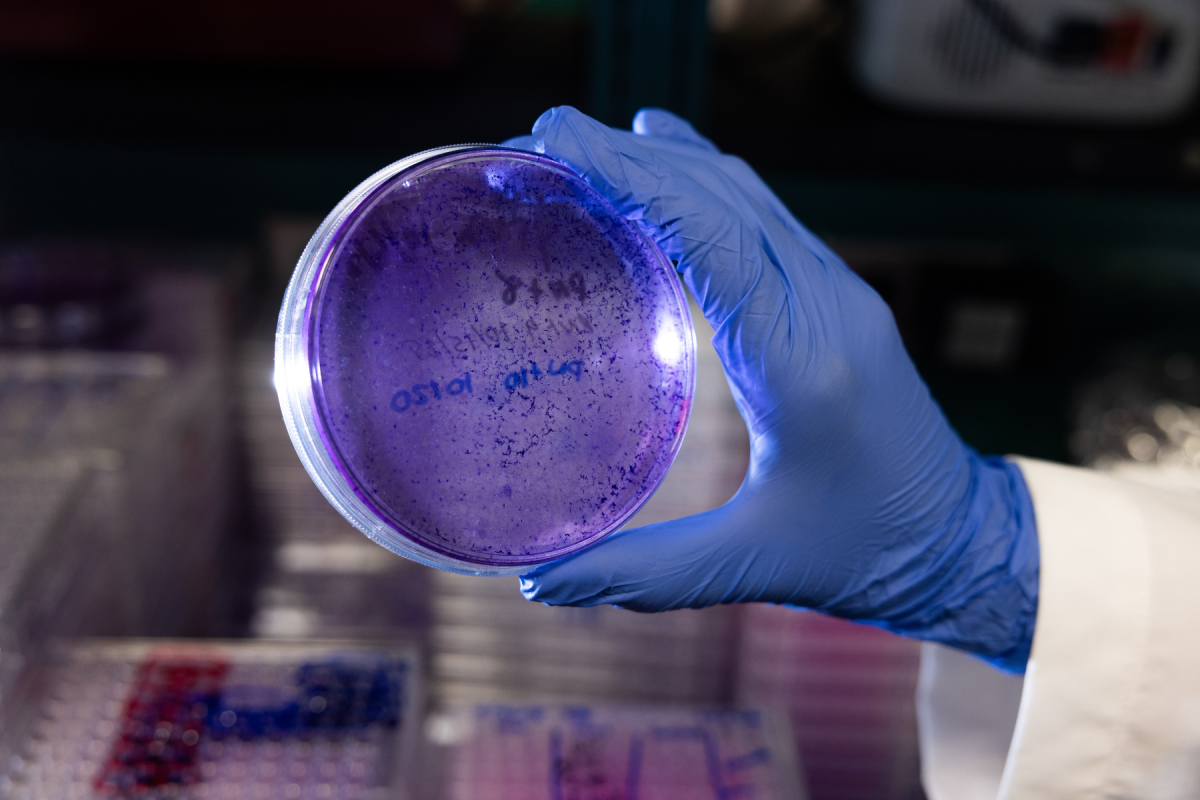
Cultured cancer cells help student and faculty researchers unlock the puzzle of drug resistance and potential therapy pathways in Daniel Chen’s cancer research lab. Photo by Chase Reynolds

Mountaineer Discovery: This story is part of a series highlighting student research, creativity and innovation at App State. Join the Office of Student Research for the 29th annual Celebration of Student Research and Creative Endeavors on Wednesday, April 22.
Gabriela Gonzalez Caquias joined Dr. Daniel Chen’s cancer lab because she knew it would offer a rigorous research experience — but she found something more. The lab’s first student member, Gonzalez Caquias helped shape the group into a small community sharing a common inquiry into one of the biggest medical challenges of our time.
“When I walk into the lab, I look forward not only to my work but also to seeing everyone, helping the newer members and being a part of a supportive and collaborative environment,” said Gonzalez Caquias, a senior from Wilmington majoring in cellular and molecular biology.
Gonzalez Caquias’s work focuses on novel compounds that can help overcome ovarian cancer resistance to chemotherapy.
“I chose to take on this research because ovarian cancer is a pressing issue for many women, and I wanted to work on something in which I could make a difference,” she said. “This lab has pushed me to grow personally and in my critical thinking skills.”
The cancer research lab team is studying the response of cancer cells to stress and ways to target those vulnerabilities through therapy regimens. Immersed in drug resistance mechanisms, metabolic vulnerabilities, and DNA damage response in ovarian and gastric cancer models, the group holds a long-term goal of contributing to more effective treatments for therapy-resistant malignancies.

Fighting for a common cause, Daniel Chen cancer lab members, from left to right, (back row): Kelly Beach, Zaw Bring, Brice Griffin, Jenna Spears, Tessa Christner, and Chloe Ledbetter. (front row): Janet Santos-Antonio, Gabriela Gonzalez Caquias, Dr. Daniel Chi-Wei Chen, Luiza Dias, and Ava Mendez. Photo by Chase Reynolds
“We are trying to improve treatment for patients who have developed a resistance to one or more drugs,” explained Ava Mendez, a senior biology major from Apex. “Drug resistance is a problem in many cancers when the cells attain mutations or find ways around it through other biological processes.”
Student success is the lab's most important mission, and mentorship and student co-authorship of published papers is strongly emphasized, said Dr. Daniel Chi-Wei Chen, assistant professor in the Department of Biology. Five of the lab’s scholars are supported in 2026 by travel grants through the Office of Student Research (OSR) to present their work, and many other lab members have had their independent projects supported by OSR research grants and other sources.
“The Chen lab undergraduate and master’s students are scientists, not observers,” said Chen. “Students take ownership of independent projects, design experiments, analyze and interpret data, write proposals, and communicate their findings in research conferences.”
A personal battle
In a world where cancer touches so many lives, lab work takes on a personal urgency. Chen’s mother was diagnosed with gastric cancer as he prepared to enter postdoctoral training. He told himself if he could make even a small difference by understanding more about cancer and especially the co-presence of multiple cancers in a single patient, that would be valuable work.
“The reality is that I learned something from my mom’s case,” he acknowledged.
Kelly Beach, a senior majoring in biology, arrived at App State with a passion for women’s health, but her work took on a personal depth due to her mother recently battling — and beating — breast cancer.
“Knowing that the research I contribute to is part of a larger fight against cancers that affect women makes every experiment feel purposeful,” said Beach, who is from Palatine, IL.

At work in the lab are App State student researchers, left to right, Janet Santos-Antonio, Kelly Beach, and Johnathan Barefoot. Photo by Chase Reynolds
Puzzles for beating cancer’s complexity
Many of the lab’s active projects are student-driven, Chen said, including studies targeting ribonucleotide reductase M2 (part of an enzyme complex critical to tumor growth) in drug-resistant cancer, evaluating combination therapies, testing new drug combinations, and identifying new pathways for cancer-fighting drugs.
“Each project functions both as a meaningful scientific contribution and as a rigorous training experience,” he explained.
Senior biology major Zaw Bring is studying the relationship between two proteins critical to cancer proliferation to see if the proteins are linked and whether targeting them in tandem could be a treatment strategy, helping support a more integrated view of cancer biology rather than treating pathways in isolation, he said.
“While (these proteins) have each been studied independently, their potential functional connection in gastric cancer is not well understood,” said Bring, of Davidson.
The lab experience helped solidify his interest in a career focused on research, particularly in the biomedical and cancer fields, Bring said.
Luiza Dias is studying how ovarian cancer cells survive stress and treatment regimens with a focus on a particular protein that makes the cancer more resilient. She plans to take the problem-solving skills gained from the cancer fight to medical school.
Even small advances in understanding can make a difference for patients, said Dias, a biology major from High Point who was born in Brazil.
“I have close relatives who have been affected by cancer, so I have seen firsthand how impactful a diagnosis can be on someone’s life,” she said. “Knowing how deeply cancer affects not just patients but their families as well makes this work feel very meaningful to me.”
Looking back on her time in the lab, Dias is able to chart not only academic and personal growth but also a deepening appreciation for research.
“Being in the lab taught me patience, adaptability, and how to work through challenges when things do not go as planned,” she said. “This experience helped me become a more confident communicator and collaborator. I went from struggling to speak in front of groups to genuinely enjoying presenting my research and working with others. Those changes have shaped how I see myself and how I approach new challenges.”

Student researchers Gabriela Gonzalez Caquias, left, and Luiza Dias discovered both rigor and community in the fight for a cure at Daniel Chen’s cancer research lab. Photo by Chase Reynolds
Skills for research frontiers
Student researcher Jenna Spears is seeing encouraging results in a project that uses the antipsychotic drug Pirenparone to reduce serotonin in cancer cells, combined with Osalmid, an inhibitor which disrupts DNA repair and synthesis. Taken together, the drugs could represent a new therapeutic pathway for treating aggressive gastric cancer, one of the deadliest forms.
“The results that I have gotten have shown that when Pirenparone is combined with Oslamid, there is a significant drop in surviving cells as opposed to these gastric cancer cells being treated with just Pirenparone or just with Oslamid,” said Spears, a senior in biology from Apex.

Students Jenna Spears, left, and Brice Griffin, right, experiment with dual-drug cancer treatments in the Daniel Chen’s cancer research lab at App State. Photo by Chase Reynolds
Spears gets a thrill of discovery and satisfaction with each result that supports her hypothesis.
“This lab research experience has been the best decision I have ever made,” she said. “I really wanted to get more involved on campus, especially in the realm of biology. I wasn’t able to join any clubs because of my schedule, but once the idea of undergraduate research was introduced to me, I knew that it was my type of extracurricular in the biology standpoint that could give me lab experience.”
By the time they have left the lab, students take with them a suite of skills which give them an edge not just in science, medicine, and biotechnology, but many careers and graduate school programs, Chen said. The end goal is to empower students to become confident, capable, and competitive scientists.
“These experiences allow students to learn grant writing, project management, and scientific accountability,” Chen said. “All of these are essential skills for future careers in science and medicine.”
Cultured cancer cells help student and faculty researchers unlock the puzzle of drug resistance and potential therapy pathways in Daniel Chen’s cancer research lab. Photo by Chase Reynolds
###
About the Department of Biology
The Department of Biology is a community of teacher-scholars, with faculty representing the full breadth of biological specializations — from molecular genetics to landscape/ecosystem ecology. The department seeks to produce graduates with sound scientific knowledge, the skills to create new knowledge, and the excitement and appreciation of scientific discovery. Learn more at biology.appstate.edu.
By Bret Yager
March 29, 2026
BOONE, N.C.